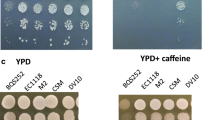

Abstract
Grape juice contains about equal amounts of glucose and fructose, but wine strains of Saccharomyces cerevisiae ferment glucose slightly faster than fructose, leading to fructose concentrations that exceed glucose concentrations in the fermenting must. A high fructose/glucose ratio may contribute to sluggish and stuck fermentations, a major problem in the global wine industry. We evaluated wine yeast strains with different glucose and fructose consumption rates to show that a lower glucose preference correlates with a higher fructose/glucose phosphorylation ratio in cell extracts and a lower K m for both sugars. Hxk1 has a threefold higher V max with fructose than with glucose, whereas Hxk2 has only a slightly higher V max with glucose than with fructose. Overexpression of HXK1 in a laboratory strain of S. cerevisiae (W303–1A) accelerated fructose consumption more than glucose consumption, but overexpression in a wine yeast strain (VIN13) reduced fructose consumption less than glucose consumption. Results with laboratory strains expressing a single kinase showed that total hexokinase activity is inversely correlated with the glucose/fructose (G/F) discrepancy. The latter has been defined as the difference between the rate of glucose and fructose fermentation. We conclude that the G/F discrepancy in wine yeast strains correlates with the kinetic properties of hexokinase-mediated sugar phosphorylation. A higher fructose/glucose phosphorylation ratio and a lower K m might serve as markers in selection and breeding of wine yeast strains with a lower tendency for sluggish fructose fermentation.
Similar content being viewed by others
Avoid common mistakes on your manuscript.
Introduction
Grape juice contains approximately equimolar amounts of glucose and fructose which are cofermented by wine yeast strains to ethanol. However, yeast strains, including wine yeasts, have a slight preference for glucose, resulting in a difference between glucose and fructose consumption (Fleet 1998). In the first phase of a wine fermentation, yeast cells are actively dividing, and because of the difference in the rate of glucose and fructose fermentation (G/F discrepancy), the difference between the remaining glucose and fructose concentrations increases linearly (Berthels et al. 2004). Later stages of alcoholic fermentation are conducted by nongrowing, metabolically active and sometimes nitrogen-starved yeast cells. Hence, in the last phase of the fermentation process, residual fructose must be fermented by nongrowing yeast cells under conditions in which ethanol levels are increasing rapidly, and most nutrients are being slowly depleted (Salmon et al. 1993; Bauer and Pretorius 2000). Under these conditions, sluggish or stuck fermentations are often associated with an excessively high fructose to glucose ratio, i.e., a ratio higher than three (Gafner and Schütz 1996; Bisson 1999). Since fructose is approximately twice as sweet to taste as glucose (Lee 1987), excess fructose can cause undesirable sweetness in wines (Boulton et al. 1996). Whether an excessive fructose to glucose ratio in the must is the main cause of sluggish and stuck fermentations is not known (Gafner and Schütz 1996).
The molecular basis of the differential utilization of glucose and fructose, i.e., the glucose/fructose discrepancy in fermentation by Saccharomyces cerevisiae, in general, is not known. We have shown previously that different wine yeast strains have strain-specific G/F discrepancies (Berthels et al. 2004), and the basis of these differences also is unknown.
The biochemical pathway underlying sugar fermentation by yeast is well established and has been studied in great detail (Zimmermann and Entian 1997). Glucose and fructose are transported by the same hexose transporters (Hxt) in the plasma membrane. Hxt6 and Hxt7 are high-affinity carriers, whereas Hxt1 and Hxt3 are low-affinity carriers. Several other Hxt carriers with intermediate affinity and whose contribution to sugar transport is not well established exist (Özcan and Johnston 1999). The V max of the Hxt carriers generally is lower for glucose transport than it is for fructose transport (Bisson 1999). In wine fermentation, genes encoding both low- and high-affinity hexose carriers are expressed, with the low-affinity Hxt1 carrier gene expressed more highly at the beginning of the fermentation, and the genes encoding the high-affinity Hxt6 and Hxt7 carriers expressed more highly in the second phase of the fermentation, after growth arrest (Perez et al. 2005). Inactivation of sugar transport could cause sluggish and/or stuck fermentations (Salmon 1989). Very recently, a mutated HXT3 allele was isolated from a commercial wine yeast strain with high fructose utilization capacity that considerably improved fructose utilization upon expression in an hxt-null strain. However, no differences in the kinetic characteristics of the mutant transporter with glucose and fructose as substrate could be detected, and its overexpression enhanced utilization of both sugars (Guillaume et al. 2007).
Once the sugars have been imported into the cell, they are phosphorylated by one of three sugar kinases Hxk1, Hxk2 and Glk1 (Entian and Barnett 1992), which differ in their glucose/fructose preference. Glucokinase only phosphorylates glucose; Hxk1 has a threefold higher V max with fructose than with glucose; Hxk2 has a slightly higher V max with glucose than with fructose (Bernard 1975; Entian and Mecke 1982). This situation is complicated further by changes in the relative phosphorylation rate of glucose and fructose by the two hexokinases with decreasing substrate concentration. The affinity of Hxk1 for glucose (K m = 0.12 mM) is higher than for fructose (K m = 1.5 mM), in spite of its higher V max with fructose. Hxk2 also has a higher affinity for glucose (K m = 0.25 mM) than for fructose (K m = 1.5 mM). Hence, the affinity for glucose is slightly higher for Hxk1 than it is for Hxk2, while the affinity for fructose is similar (Bernard 1975; Entian and Mecke 1982). In the first phase of wine fermentation, in which the yeast is actively growing, HXK2 expression is the highest. In the second phase, in which the cells may be starved for nitrogen, HXK2 expression drops, while expression of HXK1 and GLK1 increases (Varela et al. 2005). After phosphorylation, glucose-6-phosphate is converted by phosphoglucoisomerase to fructose-6-phosphate, and from this point, the metabolism of glucose and fructose are the same. Thus, there are only two steps in the fermentation pathway, transport and phosphorylation, in which differences could occur that could explain the glucose/fructose discrepancy.
The objective of this study was to investigate whether the kinetic properties of sugar phosphorylation are involved in the establishment of the G/F discrepancy in wine yeast strains, and more in particular, whether they are involved in the variation observed in this discrepancy between different strains. For this purpose, we have determined the kinetic parameters of the hexokinases in wine yeast strains with varying G/F discrepancy, and we modified hexokinase expression in laboratory strains to assess its effect on the G/F discrepancy. A better understanding of the molecular basis of the G/F discrepancy can help to select commercial yeast strains with a lower tendency for sluggish fructose fermentation and producing wines with a lower residual fructose level.
Materials and methods
Yeast strains, plasmids and primers
The yeast strains used in this study are listed in Tables 1 and 2. VIN13 is a successful commercial wine yeast strain that is used internationally for the production of especially white wines because of its good fermentative behavior and strong aroma production (Lilly et al. 2006a, b). N96 is closely related to VIN13, and VIN2000 is a mutant of VIN13 that is not sold commercially. The bacterial strain Escherichia coli DH5α (Invitrogen) was used for propagation of plasmids. The YEplac195-PGK1p/t based plasmids containing HXK1 and HXK2, both isolated from W303-1A, were constructed and provided by J. Winderickx (Leuven, Belgium). The complete open reading frames of the genes HXK1 and HXK2 were amplified by polymerase chain reaction (PCR) using the corresponding primer pairs and genomic DNA from W303-1A as a template. The amplified genes were cloned in pSTA1, a derivative of YIp5 (N. Ramachandra, Stellenbosch, South Africa), behind the constitutive PGK1 promoter. All plasmid constructions were confirmed by sequencing. The PGK1p/t-HXK1 cassette from YEplac195-PGK1p/t-HXK1 was cloned into pYC230, a plasmid containing the 2-μm replication origin, the KanMX selectable marker and a MCS (Olesen et al. 2000). The following primers were used: HXK1 FW, CATGctcgagATGGTTCATGGTCCAAAGAAACCA, (XhoI); HXK1 RE, CATGctcgagTTAAGCGCCAATGATACCAAGAGA, (XhoI); HXK2 FW, GgaattcATGGTTCATTTAGGTCCAAAAAAACC, (EcoRI) and HXK2 RE, GgaattcTTAAGCACCGATGATACCAACGG, (EcoRI).
Culture conditions
-
Bacteria.Bacterial cultures were grown at 37°C in Luria–Bertani (LB) broth (1% NaCl, 1% bacto-tryptone, 0.5% yeast extract, pH 7.5). For ampicillin resistance (ApR) selection, ampicillin was added to a final concentration of 100 μg ml−1. For solid media, 1.5% agar (Difco) was added.
-
Yeasts. Yeast cells were grown at 30°C in rich medium containing 1% yeast extract, 2% bacto-peptone and 2% glucose (YPD), or 2% fructose (YPF), or 1% glucose and 1% fructose (YPDF). Solid medium was supplemented with 1.5% agar. For hexokinase activity assays, cells were grown in YP medium supplemented with a carbon source (4% glucose, or 4% fructose, or 2% glucose and 2% fructose) to mid-exponential growth phase (OD600 nm = 1.5–2). Yeast strains transformed with a plasmid were grown at 30°C on selective minimal media (pH 5.5) containing 0.67% yeast nitrogen base without amino acids (Difco) supplemented with a synthetic dropout amino acid/nucleotide mixture as required, and 1% glucose + 1% fructose (SCDF). For solid media, the pH was adjusted to 6.5, and 1.5% agar (Difco) was added. For KANr selection of VIN13 transformed with HXK1 on a plasmid, geneticin was added to a final concentration of 300 μg ml−1. In all experiments, strains with identical auxotrophies were used to avoid any marker effects on growth. Empty plasmids were introduced as a control.
Growth curves and medium sugar determination
For growth curves, late exponential phase cells were diluted to an optical density (measured at a wavelength of 600 nm; OD600 nm) of 0.1 in fresh SCDF growth medium. Growth was followed by measuring the optical density at different time points. Glucose and fructose concentrations in samples taken during growth experiments were determined using the d-glucose/d-fructose test kit (Boehringer Mannheim).
Molecular biology methods
Standard procedures for the isolation and manipulation of DNA were used throughout this study (Ausubel et al. 1994). Restriction enzymes (Fermentas), T4 DNA-ligase and Expand Hi-Fidelity DNA polymerase (Roche) were used in the enzymatic manipulation of DNA as recommended by the supplier. DNA sequencing and primer construction were performed by Inqaba Biotech (Johannesburg, South Africa). Bacterial transformations were done according to the CaCl2 method (Sambrook et al. 1989). Yeast transformations were done according to the lithium–acetate method (Gietz et al. 1995).
Hexokinase activity assay
Hexokinase activity was measured spectrophotometrically in crude cell extracts using Roche chemicals (Hohmann et al. 1999). Cells were harvested under equivalent physiological conditions and washed in imidazole buffer (pH 7.0). Two milliliters of buffer with 1 mM PMSF and glass beads (Ø 0.75 mm) were added to the cell suspension. The cells were broken by vigorous shaking of the suspension on a vortex for 2 min at 4°C. After vortexing, the cell extract was transferred to a microcentrifuge tube and centrifuged for 5 min at 1,000 rpm. A maximum of 200 μl of the extract was used for the determination of hexokinase activity (approximately 1 μg protein μl−1). The appropriate amount of cell extract was mixed with buffer to obtain a volume of 200 μl and this final volume transferred to a microtiter plate. For 20 samples, the following mixture was prepared: 2 ml imidazole buffer, 160 μl ATP 50 mM (in HEPES, 200 mM pH 7.6), 4 μl glucose-6-P dehydrogenase (0.6 U), 80 μl NADP+ 40 mM (in HEPES, 200 mM pH 7.6), 8 μl phosphoglucoisomerase (2 U) and water up to 4 ml. An amount of 200 μl of this mixture was added to each extract sample. The microtiter plate was put in a Biomek 2000 robot (Beckman). Glucose or fructose solution in the appropriate concentration was added. The kinetic parameters were evaluated in the following concentration range: 0.1, 0.2, 0.5, 1.0, 2.0, 3.0, 5.0 and 10.0 mM. The changes in the NADPH absorbance (OD340 nm) were measured automatically at 30 s intervals for 3 min after the addition of glucose or fructose. The protein concentrations in the crude extracts were determined using the Bradford method with bovine serum albumin as a standard (Bradford 1976). Hexokinase activity was calculated as nmol NADPH min−1 (mg protein)−1. The kinetic parameters V max and K m were determined by nonlinear regression analysis using the Graph pad Prism program.
Calculation of the G/F discrepancy
We have observed previously that the difference between the remaining glucose and fructose concentrations increases linearly between the time points where 20 and 50% of the glucose in the medium has been consumed (Berthels et al. 2004). Hence, we calculated the G/F discrepancy for different strains as the difference in the rate of glucose and fructose fermentation during this time period. The kinetic properties of sugar phosphorylation have been determined at mid-exponential phase which is the same time period in which the G/F discrepancy has been calculated.
Reproducibility of the results
All experiments were repeated two to three times with independent cultures or transformants. SDs are shown for comparisons between independent data points (kinetic parameters). Representative results are shown for comparisons between collections of interdependent data points (time course measurements). The latter experiments were performed twice with consistent results for two independent cultures each. The data in the examples shown are the means of two independent cultures from a single experiment.
Results
Kinetic properties of hexokinase in wine yeast strains
In previous work, wine yeast strains were classified according to their inherent discrepancy in glucose vs fructose consumption rates (Berthels et al. 2004). The G/F discrepancy for different strains is calculated as the difference in the rate of glucose and fructose fermentation (see Materials and methods section). For the purpose of this study, three strains that cover the full spectrum of observed G/F discrepancies were used: VIN2000 (small), VIN13 (medium) and N96 (high) (Berthels et al. 2004). Specific hexokinase activity in cell extracts with glucose or fructose as substrate was determined for the three strains grown in a medium with either glucose, fructose or an equimolar mixture of the two sugars as carbon source. The ratio of fructose to glucose phosphorylation activity (Q F /G) was highest for the VIN2000 strain when yeast cells were grown on fructose or an equimolar mixture of the two sugars (Table 3). However, when grown on glucose, N96 had the highest Q F /G. There was a general trend for a higher Q F /G in the strains with a lower G/F discrepancy, in particular, under conditions that best mimic actual wine fermentation conditions (glucose + fructose). As the kinetic properties of the three kinases differ, the differences in Q F /G in the three strains might be due to differences in relative expression of the corresponding genes. Alternatively, specific mutations in the hexokinase enzymes might alter their kinetic properties or their stability and turnover.
We determined the kinetic parameters, K m and V max, of hexose phosphorylation in cell extracts of the three wine yeast strains, grown in a medium with either glucose, fructose or an equimolar mixture of the two sugars as carbon source. As previously reported for laboratory strains (Bernard 1975; Entian and Barnett 1992; Entian and Mecke 1982), the K m for glucose was always lower than the K m for fructose (Table 4). The VIN2000 strain, which had the lowest G/F discrepancy, also had the lowest K m values both for glucose and fructose. The K m values for glucose and fructose correlated with the G/F discrepancy: K m for VIN2000 < K m for VIN13 < K m for N96. Thus, there is no preferential reduction in K m for fructose in strains with lower G/F discrepancy.
There was no correlation between the V max values for glucose and fructose phosphorylation and the G/F discrepancy of the strains (Table 4). For instance, there was no consistent order in the V max values when going from a strain with low G/F discrepancy to a strain with high G/F discrepancy, neither in glucose and fructose medium nor in the medium with an equimolar mixture of the two sugars. As the free intracellular level of the two sugars probably never approaches values sustaining maximal rates of sugar phosphorylation that occur at V max, it is not surprising that there is no correlation between the V max values and the G/F discrepancy. Surprisingly, the V max values of sugar phosphorylation in extracts of cells grown in an equimolar mixture of glucose and fructose were only about half of those obtained for extracts of cells grown in pure glucose or fructose media.
Modification of hexokinase activity and G/F discrepancy in a laboratory strain
We overexpressed HXK1 and HXK2 (using the PGK1 promoter and a multicopy plasmid) in the laboratory strain W303-1A. Hexokinase activity (10 mM fructose as substrate) was 5,300 ± 400, 1,800 ± 600 and 130 ± 10 nmol min−1 mg protein−1 for W303-1A transformed with HXK1, HXK2 and the vector, respectively. We determined the effect on the G/F discrepancy for fermentation of an equal weight glucose/fructose mixture (each 1%). Overexpression of either HXK1 or HXK2 had no significant effect on growth (Fig. 1a). Overexpression of HXK1 increased fructose consumption more than glucose consumption (Fig. 1a), confirming that the Q F /G of sugar phosphorylation is a determinant of the G/F discrepancy. Consistent with this hypothesis, overexpression of HXK2 did not alter the G/F discrepancy, although unexpectedly, it did not increase fermentation of the two sugars (Fig. 1b).
Effect of overexpression of HXK1 (a) or HXK2 (b) in the wild-type strain W303-1A on fermentation of a mixture of glucose and fructose (each 10 g l−1). Glucose (λ, ○) and fructose (σ, △) level in the medium. Growth as measured by OD600 (ν, □). Strains: W303-1A + YEplac195 (λ, σ, ν), W303-1A + HXK1 or HXK2 (○, △, □). This experiment was performed twice with consistent results for two independent cultures each. The data in the example shown are the means of two independent cultures from a single experiment
We also overexpressed HXK1 and HXK2 in the hxk1Δ hxk2Δ glk1Δ strain with the W303-1A background to determine the G/F discrepancy in a strain expressing only a single hexokinase. Hexokinase activities (10 mM fructose as substrate) were 4,700 ± 150, 1,100 ± 350 and 1.5 ± 0.1 nmol min−1 mg protein−1 for the hxk1Δ hxk2Δ glk1Δ strain transformed with HXK1, HXK2 and the vector, respectively. The results clearly show that in strains expressing only HXK1 or only HXK2, fructose fermentation proceeds slower than glucose fermentation (Fig. 2). This confirms that the relative V max for glucose and fructose phosphorylation does not determine the relative rate of fermentation of the two sugars. The hxk1Δ hxk2Δ glk1Δ + HXK1 strain fermented both sugars slower than the wild-type strain, and the consumption rate for the two sugars was about equally affected (Fig. 2a). Possibly, the defect in glucose repression caused by hxk2Δ could be responsible for the difference with the wild-type strain overexpressing HXK1. Interestingly, the hxk1Δ hxk2Δ glk1Δ + HXK2 strain fermented fructose significantly faster than a wild-type strain (Fig. 2b). However, this was only true in the second phase of the fermentation when the glucose level had dropped to very low values. Glucose consumption in the second phase of the fermentation, on the other hand, was only slightly faster than in the wild-type strain (Fig. 2b). These results indicate that an increase in the total fructose phosphorylating activity can significantly stimulate the fermentation of low fructose levels. Apparently, hexokinase activity becomes only limiting when the intracellular sugar levels have dropped to low values, probably to values below the K m of the hexokinases for glucose or fructose phosphorylation.
Effect of overexpression of HXK1 (a) or HXK2 (b) in the hxk1Δ hxk2Δ glk1Δ strain on fermentation of a mixture of glucose and fructose (each 10 g l−1). Glucose (λ, ○) and fructose (□, △) level in the medium. Growth as measured by OD600 (ν, □). Strains: Wild-type W303-1A + YEplac195 (λ, σ, ν), hxk1Δ hxk2Δ glk1Δ + HXK1 or HXK2 (○, △, □). This experiment was performed twice with consistent results for two independent cultures each. The data in the example shown are the means of two independent cultures from a single experiment
Overexpression of HXK1 and G/F discrepancy in the VIN13 wine yeast strain
HXK1 was also overexpressed in the VIN13 wine yeast strain (using the PGK1 promoter and a multicopy plasmid). Hexokinase activity (10 mM fructose as substrate) was 8,700 ± 2,600 and 1,000 ± 40 nmol min−1 mg protein−1 for VIN13 transformed with HXK1 and vector, respectively. As opposed to overexpression of HXK1 in the laboratory strain W303-1A, this caused a reduction in the rate of glucose consumption (from 3.66 to 2.66 g l−1 h−1) and fructose consumption (from 1.64 to 1.61 g l−1 h−1). The growth rate was also reduced with both sugars. As glucose consumption was affected more than fructose consumption, the net result was a decrease in the G/F discrepancy. The difference with the laboratory strain for the effect of overexpression might be related to the higher hexokinase activity level reached in the commercial strain. The PGK promoter used might be more active in the commercial strain than in the laboratory strain. The latter strains are well-known to have lower fermentative activity than commercial strains. Hexokinase activity in yeast is controlled by the Tps1 enzyme that synthesizes trehalose-6-phosphate. A tps1Δ strain displays hyperactive sugar phosphate accumulation in vivo resulting in inability to grow on rapidly fermented sugars (Thevelein and Hohmann 1995). Overexpression of hexokinase in a laboratory strain has been shown to cause a transient sugar phosphate accumulation, mimicking the metabolic deregulation observed in a tps1Δ strain but only for a short time after glucose addition (Ernandes et al. 1998). Possibly, the very high activity in the VIN13 strain with HXK1 overexpression causes, to some extent, a similar tps1Δ-like deregulation of sugar phosphate accumulation resulting in growth inhibition.
Discussion
In this paper, we have investigated whether the variation in the differential consumption of glucose and fructose (GF discrepancy) by different wine yeast strains might be related to differences in the kinetic properties of their glucose and fructose phosphorylating enzymes. A recent paper has concentrated instead on the possible role of sugar transport in determining the glucose/fructose preference. The authors isolated a mutated HXT3 allele from a commercial wine yeast strain with superior fructose consumption capacity that resulted in an improved fructose utilization rate upon expression in an hxt-null strain (Guillaume et al. 2007). However, the kinetic characteristics of the mutated Hxt3 transporter with glucose and fructose as substrates were not altered compared to the wild-type allele. Hence, it remains unclear what property of the mutated HXT3 allele was responsible for the improved fructose utilization. In addition, it was not established that the HXT3 mutation was the only genetic determinant of the high fructose utilization capacity in the commercial wine yeast strain.
The kinetic properties of sugar phosphorylation in vivo are the result of the properties of three enzymes: glucokinase, hexokinase 1 and hexokinase 2. As the kinetic properties of the three enzymes differ considerably, their expression level will have a major influence on the kinetic properties of in vivo sugar phosphorylation. An additional complication is that the commercial wine yeast strains used are diploid and may contain two different alleles for HXK1, HXK2 and GLK1. We have measured total hexokinase activity and the kinetic parameters in cell extracts of cells grown on glucose, fructose or a mixture of glucose and fructose. The latter condition best reflects the actual wine fermentation condition, although the sugar levels are much higher, and the nitrogen levels much lower in real wine fermentations. Measurements with the mixture of isozymes in cell extracts also best reflects the actual situation in vivo with respect to glucose phosphorylation activity and kinetics.
We found that lower K m values for both sugars correlate with a lower G/F discrepancy in wine yeast strains with varying G/F discrepancies. The ratios between the K m for glucose and the K m for fructose were not significantly different between the three wine yeast strains used. Thus, it is not immediately clear how the lowered K m values for both sugars are related to the smaller G/F discrepancy. A possible explanation could be given by the relationship between the K m values and the intracellular level of the sugars. The K m for low-affinity transport of glucose (20 mM) is lower than that for low-affinity transport of fructose (40 mM), while the V max of fructose transport generally is higher than the V max for glucose transport (Bisson 1999). Low-affinity transport is present in glucose-repressed yeast cells responsible for most of the wine fermentation. At lower sugar levels in the medium, the intracellular concentration of fructose in wine yeast is probably lower than that of glucose because of the higher K m of fructose transport. The intracellular glucose concentration is known to be very low (2 to 3 mM) in laboratory yeast cells (Teusink et al. 1998). Its precise measurement in the presence of high extracellular sugar concentrations, however, is technically difficult. Values for free intracellular fructose have not been reported in the literature. This is probably due to the fact that yeast fermentations are rarely performed with fructose as substrate. The K m for glucose of the hexokinases is substantially lower than that for fructose (Bernard 1975; Entian and Barnett 1992; Entian and Mecke 1982), so the K m for glucose might be lower than the intracellular glucose concentration, whereas the K m for fructose might be similar or higher than its intracellular level. Consequently, a similar relative decrease in the K m value for glucose and fructose could increase the phosphorylation of fructose more than that of glucose, thereby reducing the G/F discrepancy. In a real wine fermentation, this explanation can only be valid in the final phase when the sugar levels have dropped to low values. The glucose and fructose concentration in wine must are each around 110 g l−1, which corresponds to about 630 mM. In spite of these very high sugar concentrations and obvious saturation of the sugar transport systems, the discrepancy between glucose and fructose fermentation is already evident early in the wine fermentation process.
As opposed to overexpression of Hxk1, overexpression of Hxk2 did not increase the fermentation rate. The latter result is consistent with a previous study in which the effect of individual overexpression of most of the glycolytic enzymes (except Hxk1) on the rate of glucose fermentation was determined (Schaaff et al. 1989). The absence of a stimulation of fermentation by overexpression of Hxk2 may be due to its higher sensitivity for inhibition by trehalose-6-phosphate (Blazquez et al. 1993), so that overexpression of Hxk2 could have little effect on the actual in vivo hexokinase activity. The somewhat higher K m of Hxk2 compared to that of Hxk1 could also explain part of the difference.
We conclude that the G/F discrepancy in S. cerevisiae is not related to the maximal hexokinase activity in vitro with glucose or fructose as substrate or to the ratio between the K m values for glucose and fructose phosphorylation but might rather be related to the actual fructose phosphorylating activity at physiological fructose levels in vivo. This is reflected in the apparent correlation of the K m for fructose phosphorylation and the specific hexokinase activity observed with fructose as substrate. The higher fructose/glucose phosphorylation ratio and lower K m values might serve as markers in selection and breeding of wine yeast strains with a lower tendency for sluggish fructose fermentation.
References
Ausubel FM (1994) Current protocols in molecular biology. Wiley, New York
Bauer FF, Pretorius IS (2000) Yeast stress response and fermentation efficiency: how to survive the making of wine - A review. S Afr J Enol Vitic 21:27–51
Bernard EA (1975) Hexokinases from yeast. Methods Enzymol 42:6–20
Berthels NJ, Cordero Otero RR, Bauer FF, Thevelein JM, Pretorius IS (2004) Discrepancy in glucose and fructose utilisation during fermentation by Saccharomyces cerevisiae wine yeast strains. FEMS Yeast Res 4:683–689
Bisson LF (1999) Stuck and sluggish fermentations. Am J Enol Vitic 50:107–119
Blazquez MA, Lagunas R, Gancedo C, Gancedo JM (1993) Trehalose-6-phosphate, a new regulator of yeast glycolysis that inhibits hexokinases. FEBS Lett 329:51–54
Boulton RB, Singleton VL, Bisson LF, Kunkee RE (1996) Yeast and biochemistry of ethanol fermentation. In: Boulton RB, Singleton VL, Bisson LF, Kunkee RE (eds) Principles and practices of winemaking. Chapman and Hall, New York, pp 139–172
Bradford MM (1976) A rapid and sensitive method for the quantitation of microgram quantities of protein utilizing the principle of protein-dye binding. Anal Biochem 72:248–254
De Winde JH, Crauwels M, Hohmann S, Thevelein JM, Winderickx J (1996) Differential requirement of the yeast sugar kinases for sugar sensing in establishing the catabolite-repressed state. Eur J Biochem 241:633–643
Entian KD, Mecke D (1982) Genetic evidence for a role of hexokinase isozyme PII in carbon catabolite repression in Saccharomyces cerevisiae. J Biol Chem 257:870–874
Entian KD, Barnett JA (1992) Regulation of sugar utilization by Saccharomyces cerevisiae. Trends Biochem Sci 17:506–510
Ernandes JR, De Meirsman C, Rolland F, Winderickx J, de Winde J, Brandao RL, Thevelein JM (1998) During the initiation of fermentation overexpression of hexokinase PII in yeast transiently causes a similar deregulation of glycolysis as deletion of Tps1. Yeast 14:255–269
Fleet GH (1998) The microbiology of alcoholic beverages. In: Wood BJB (ed) Microbiology of fermented foods. Blackie, Glasgow, pp 217–262
Gafner J, Schütz M (1996) Impact of glucose–fructose-ratio on stuck fermentations: practical experiences to restart stuck fermentations. Vitic Enol Sci 51:214–218
Gietz RD, Schiestl RH, Willems AR, Woods RA (1995) Studies on the transformation of intact yeast cells by the LiAc/SS-DNA/PEG procedure. Yeast 11:355–360
Guillaume C, Delobel P, Sablayrolles JM, Blondin B (2007) Molecular basis of fructose utilization by the wine yeast Saccharomyces cerevisiae: a mutated HXT3 allele enhances fructose fermentation. Appl Environ Microbiol 73:2432–2439
Hohmann S, Winderickx J, de Winde JH, Valckx D, Cobbaert P, Luyten K, De Meirsman C, Ramos J, Thevelein JM (1999) Novel alleles of yeast hexokinase PII with distinct effects on catalytic activity and catabolite repression of SUC2. Microbiology 145:703–714
Lee CK (1987) The chemistry and biochemistry of the sweetness of sugars. Adv Carbohydr Chem Biochem 45:199–351
Lilly M, Bauer FF, Lambrechts MG, Swiegers JH, Cozzolino D, Pretorius IS (2006a) The effect of increased yeast alcohol acetyltransferase and esterase activity on the flavour profiles of wine and distillates. Yeast 23:641–659
Lilly M, Bauer FF, Styger G, Lambrechts MG, Pretorius IS (2006b) The effect of increased branched-chain amino acid transaminase activity in yeast on the production of higher alcohols and on the flavour profiles of wine and distillates. FEMS Yeast Res 6:726–743
Olesen K, Franke Johannesen P, Hoffmann L, Bech Sorensen S, Gjermansen C, Hansen J (2000) The pYC plasmids, a series of cassette-based yeast plasmid vectors providing means of counter-selection. Yeast 16:1035–1043
Özcan S, Johnston M (1999) Function and regulation of yeast hexose transporters. Microbiol Mol Biol Rev 63:554–569
Perez M, Luyten K, Michel R, Riou C, Blondin B (2005) Analysis of Saccharomyces cerevisiae hexose carrier expression during wine fermentation: both low- and high-affinity Hxt transporters are expressed. FEMS Yeast Res 5:351–361
Salmon JM (1989) Effect of sugar transport inactivation in Saccharomyces cerevisiae on sluggish and stuck enological fermentations. Appl Environ Microbiol 55:953–958
Salmon JM, Vincent O, Mauricio JC, Bely M, Barre P (1993) Sugar transport inhibition and apparent loss of activity in Saccharomyces cerevisiae as a major limiting factor of enological fermentations. Am J Enol Vitic 44:56–64
Sambrook J, Fritsch EF, Maniatis T (1989) Molecular cloning: a laboratory manual, 2 edn. Cold Spring Harbor Laboratory, Cold Spring Harbor, New York
Schaaff I, Heinisch J, Zimmermann FK (1989) Overproduction of glycolytic enzymes in yeast. Yeast 5:285–290
Teusink B, Diderich JA, Westerhoff HV, van Dam K, Walsh MC (1998) Intracellular glucose concentration in derepressed yeast cells consuming glucose is high enough to reduce the glucose transport rate by 50%. J Bacteriol 180:556–562
Thevelein JM, Hohmann S (1995) Trehalose synthase: guard to the gate of glycolysis in yeast? Trends Biochem Sci 20:3–10
Thomas BJ, Rothstein R (1989) Elevated recombination rates in transcriptionally active DNA. Cell 56:619–630
Varela C, Cardenas J, Melo F, Agosin E (2005) Quantitative analysis of wine yeast gene expression profiles under winemaking conditions. Yeast 22:369–383
Zimmermann FK, Entian KD (eds) (1997) Yeast sugar metabolism. Technomic, Lancaster, Pennsylvania, USA
Acknowledgments
We thank Willy Verheyden for technical assistance and Nico Van Goethem for help with the preparation of the figures. This work was supported by grants from the National Research Foundation and Winetech in South Africa to I.S.P., by the Research Fund of the Katholieke Universiteit Leuven (Flanders-South Africa project BIL02/34) to J.M.T. and I.S.P. and Concerted Research Actions to J.M.T.
Author information
Authors and Affiliations
Corresponding author
Rights and permissions
About this article
Cite this article
Berthels, N.J., Cordero Otero, R.R., Bauer, F.F. et al. Correlation between glucose/fructose discrepancy and hexokinase kinetic properties in different Saccharomyces cerevisiae wine yeast strains. Appl Microbiol Biotechnol 77, 1083–1091 (2008). https://doi.org/10.1007/s00253-007-1231-2
Received:
Revised:
Accepted:
Published:
Issue Date:
DOI: https://doi.org/10.1007/s00253-007-1231-2